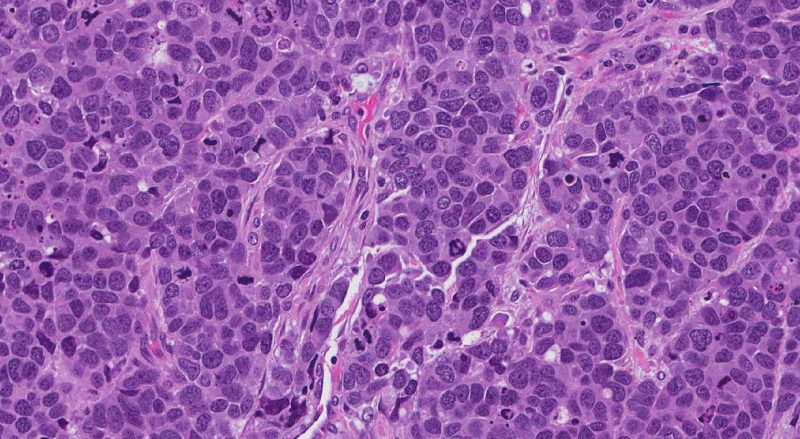
KARZINOGENESE KARZINOGENESE

KARZINOGENESE
Beginnen wir mit den Ursprüngen der Probleme. Basierend auf der Tatsache, dass die Anzahl aktivierter Gene in einem erwachsenen Organismus signifikant reduziert ist und nur ein kleiner Teil der Anzahl identischer Gene in einer Zelle aktiviert ist, macht dies (quantitativ) nur einen Bruchteil von einem Prozent für den gesamten Organismus aus. Im Normalzustand muss die überwiegende Mehrheit der Gene vor einer Aktivierung geschützt werden, was nur möglich ist, wenn sie sich zwischen den aktiven Zonen des akustischen Feldes des Kerns befinden.
Aufgrund der unsachgemäßen Kontrolle des Transkriptionsprozesses liegt eine Verletzung des Schutzes der Gene vor ihrer Aktivierung vor.
Die Dissonanz des Genoms mit dem Wellenfeld verursacht eine Verschiebung des Chromatins relativ zu den aktiven Zonen, was zu einer Verletzung der Aktivierungsaktivierung führt, mit einem raschen Übergang zu einer chaotischen Zunahme der Anzahl der transkribierten Gene. Diese Situation ist das charakteristischste Merkmal fast jeder Krebsentstehung. Es kann argumentiert werden, dass in all diesen Fällen die normale Anordnung von Genen im Raum des Kerns gestört ist.
Es gibt viele Gründe für solche Verstöße. Bei der Einführung von Viren, die Gene direkt ersetzen, kann es zu einer Fehlpaarung kommen.
Im Übrigen sind bakterielle Infektionen weniger komplex, da sie im Gegensatz zu viralen Infektionen die holographische Konfiguration des Genoms nicht beeinflussen und daher nicht direkt zum Auftreten von bösartigen Tumoren führen.
Es besteht auch die Möglichkeit von Krebs bei Trisomie und anderen Chromosomenstörungen.
In somatischen Körperzellen treten manchmal Chromosomenumlagerungen während der Mitose auf, von denen ein Großteil zur Karzinogenese führen kann.
Eine der Hauptursachen für Störungen der normalen Position des Chromatins im Kern ist eine Dissonanz zwischen dem Wellenfeld des Kerns und den Koordinaten der Gene, die zu Chromosomenanomalien führt.
Die Kerne von mehrzelligen Organismen haben in der Regel eher die Form eines Sphäroids als eine Kugel, was die Ausrichtung des Genoms auf die Projektion des menschlichen Körpers, der ebenfalls eine längliche Form aufweist und gegen die „Erklärung von Form und Orientierung“ verstößt, erheblich verbessert.
Dies legt nahe, dass alle menschlichen Tumorzellen ausnahmslos unterschiedliche Chromosomenanomalien aufweisen (einschließlich Translokationen, Deletionen und Duplikationen).
Sehr oft geht die Karzinogenese mit schwerwiegenden Verzerrungen der Kernmembran oder Deformationen des Kerns einher, beispielsweise unter dem Druck von Hormonen, die das Zellgranulat überwältigen. Offensichtlich gibt es Verzerrungen in Form eines Kerns mit einer ihm nicht eigenen Kontur, eine Invagination oder das Vorhandensein von Fremdformationen in der Zelle, die verhindern, dass der Kern die gewünschte Form oder Position frei annimmt.
Krebs kann aus verschiedenen Gründen auftreten, sammelt sich jedoch in Zellen so an, dass er abnormale Kreuzkonfigurationen bildet, die durch den normalen Verlauf der Zelldifferenzierung einer bestimmten Zelllinie nicht bereitgestellt werden. Die Diskrepanz zwischen dem Genom und dem Wellenfeld führt somit zu einem spontanen Übergang einer bestimmten Anzahl zufällig ausgewählter D-Gene in einen kreuzförmigen Zustand, wonach die normale Entwicklung von Tochterzellen gestört wird, wobei die Chromatinkonfiguration mit dem charakteristischen Wellenfeldmuster grundsätzlich unverträglich wird. Darüber hinaus weicht die Zelllinie mit jedem weiteren Differenzierungsschritt zunehmend von der Struktur des Wellenfeldes ab und verstärkt den bösartigen Prozess. Es ist überraschend, aber hier ist es möglich, zur Ausgangsebene zurückzukehren – dem Beginn der Genealogie von Zelltypen mit linearen Doppelspiralen. Solche Faktoren können manchmal unabhängig voneinander einbezogen werden, und wenn sie ihre biophysikalische Natur verstehen, kann ein solcher Prozess speziell für die Entwicklung (Remission) initiiert werden, wonach das Genom für die korrekte, gesunde Bildung des betroffenen Organs und des gesamten Organismus bereit ist.
Der Hauptunterschied zwischen den Zellen von bösartigen Tumoren liegt in der Störung der normalen Koordination der Gene innerhalb der Kerne, in der Verzerrung der eigentlichen Konfiguration des Genoms, und die Antikörper reagieren überhaupt nicht auf solche Unterschiede.
Folglich ist das Risiko einer Karzinogenese viel größer und gefährlicher als bei allen tödlichen Infektionen, da das körpereigene Immunsystem es nicht bekämpft. Sie bemerkt diese Bedrohung einfach nicht.
Der Grund hierfür ist nach dem Konzept der Strukturgenese völlig offensichtlich und nachvollziehbar. Das Immunsystem kann erst nach der Erkennung von Eindringlingen reagieren, die durch das entsprechende Antikörpersystem ausgelöst wird. Das Immunsystem, das fremde Moleküle, Zellen und Gewebe bekämpfen soll, unterscheidet Zellen mit einer gestörten Anordnung von Genen in den Kernen überhaupt nicht von anderen Zellen eines bestimmten Organismus.
Diese Tatsache kann die unvermeidlichen Misserfolge im Kampf gegen Krebs mit Hilfe von Impfungen erklären. Das Immunsystem kämpft selten und sehr selektiv gegen bösartige Tumoren und reagiert sehr träge auf einige sekundäre, wenig untersuchte Anzeichen transformierter Zellen.
Mutagenese von Karzinogenen
Wie allgemein angenommen wird, erklärt sich die Wirkung chemischer Karzinogene durch ihre mutagene Aktivität. Dies ist das Grundkonzept, auf dem die Methode zur Prüfung von Chemikalien auf Karzinogenität basiert.
Natürlich kann man nicht behaupten, dass Mutationen krebserzeugend sein können. Aber es gibt einige Nuancen, die es wert sind, erwähnt zu werden.
Die erste davon ist, dass die Anzahl der malignen Zellregenerationen aufgrund der Wirkung einer bestimmten Substanz immer signifikant höher ist als die Häufigkeit der Mutationen, die von dieser Substanz unter den gleichen Bedingungen verursacht werden. Es ist daher logisch anzunehmen, dass der Hauptwirkungsmechanismus chemischer Karzinogene nicht in der Auslösung von Mutationen und nicht in einer lokalen DNA-Schädigung besteht, sondern in einer direkten Störung der allgemeinen räumlichen Korrespondenz zwischen dem Chromatin des Kerns und dem Wellenfeld.
Die zweite Nuance ergibt sich aus den Ergebnissen vieler Studien, nach denen festgestellt wurde, dass es für eine klare Manifestation der Transformation erforderlich ist, dass die Zelle nach der Wirkung eines Karzinogens mindestens eine Teilung durchläuft.
Wenn sich bereits in einer Zelle eine Mutation eines Gens oder regulatorischer Bereiche der DNA eindeutig manifestiert, wird bei der Konfiguration von D-Genen eine völlig andere Situation beobachtet. Die Quintessenz ist, dass, wenn ein DNA-Palindrom seine Konfiguration geändert hat, dies nur nach der Zellteilung während des anschließenden Zusammenbaus des Chromatins der davon abgeleiteten Zellkerne wichtig sein kann.
Wichtig ist auch, dass die Häufigkeit der malignen Transformation von Zellen in der Regel stark schwankt, während die Häufigkeit von Mutationen relativ konstant ist.
So wurde in mehreren unabhängigen Studien festgestellt, dass die Transformation embryonaler Zellen unter der Einwirkung von Benzapyren oder Methylnitrosoguanidin stark schwankt und die stabile Häufigkeit von Mutationen zur Resistenz gegen Oubain im selben System um das 30- bis 450-fache überschreitet!
Die dritte interessante Nuance zeigt sich am Ende mehrerer Experimente zur Kultivierung eines völlig gesunden Frosches auf der Basis des Kerns einer Tumorzelle, die in das Zytoplasma eines Eies transplantiert wurde. Ebenso repetitive Ergebnisse passen nicht zu der Vorstellung, dass der Tumor durch eine Mutation verursacht wird, da diese Mutation durch den Transfer des Zellkerns in das Zytoplasma des Eies nicht verschwinden könnte. Man kann einen deutlichen Unterschied zum wahrscheinlichen Muster erkennen, wenn DNA-Palindrome, die von einem Karzinogen in einen ungewöhnlichen “Kreuz” -Zustand übersetzt wurden, höchstwahrscheinlich zur ursprünglichen linearen Konfiguration zurückkehren könnten.
Natürlich werden wir versuchen, diese Art von Wirkungsmechanismus chemischer Karzinogene auf die Konfiguration von DNA-Palindromen vollständig zu untersuchen, um ein wirksames Mittel zur Neutralisierung eines solchen Effekts zu finden, das es ermöglicht, das “chemische” Segment der
Karzinogenese zu verhindern.
Ich möchte auf eine weitere merkwürdige Tatsache in Bezug auf die erhöhte Anzahl aktivierter Gene in malignen Zellen aufmerksam machen, die sich in allen relevanten Experimenten manifestiert. Als typisches Beispiel kann ein Prozess angeführt werden, der in Kulturen von Tumorzellen vom HeLa-Typ auftritt, in denen die Hälfte der synthetisierten m-RNA aus etwa 35.000 verschiedenen Genen transkribiert wird. Dies ist natürlich zu viel, was eindeutig nicht den normalen Bedürfnissen der Zelle entspricht.
Auf den ersten Blick scheint dies dem allgemein akzeptierten Konzept zu widersprechen, wonach Karzinogenese mit der Aktivität der anomalen Gene verbunden ist, die abnormale Proteine produzieren. Aber hier gibt es keinen Widerspruch. Beispielsweise wird in einer der Arbeiten von Hunter D. über Proteinkinase p60src berichtet, die vom src-Onkogen aus dem Rous-Sarkom-Virus codiert wird. Dieses Protein unterscheidet sich von der normalen Proteinkinase dadurch, dass an der Stelle von der 515. bis zur 526. Aminosäure eine andere Sequenz eingefügt ist, die aus 19 Aminosäuren besteht. Infolgedessen phosphoryliert das Onkogenprodukt ausschließlich Tyrosin, wenn eine normale Proteinkinase eine Phosphatgruppe hauptsächlich an Serin- oder Threoninprotein bindet.
Die Übertragung von Phosphatgruppen von ATP auf Protein gibt dem Protein die Energie, die erforderlich ist, um seine Arbeitsfunktionen auszuführen, und die Verzerrung einer solchen Übertragung stört die Funktion des Proteins. In der Tat wurde in der oben genannten Studie gezeigt, dass die Funktion eines der Zytoskelettproteine, Vinculin, das für die Anlagerung von Aktinfibrillen an die Membranen verantwortlich ist, und des p36-Proteins des terminalen Plexus des Filaments, das die Bewegung der Darmmikrovilli der Mikrovilli steuert, beeinträchtigt ist.
Es ist davon auszugehen, dass auch andere Funktionen des Zytoskeletts verletzt werden, darunter die Regulation der Form und Orientierung des Kerns. Anscheinend ist das Onkogen hier eine Art “Auslöser”, der das Genom dazu veranlasste, mit dem Wellenfeld in Konflikt zu geraten, und dann entwickelt sich alles nach dem obigen Schema.
Mit dem schnellen Wachstum der Gesamtintensität der Biosynthese und einer Zunahme des Volumens des Zytoplasmas nimmt die Intensität jedes einzelnen Prozesses im Durchschnitt ab. Die Hüllensynthese wird ebenfalls eingeebnet, wodurch die Größe der Zellwand chronisch hinter dem Wachstum des Zytoplasmas zurückbleibt, was die Ausbreitung bösartiger Zellen erschwert.
Die Versorgung einer normalen Zelle mit Nährstoffen wird unterbrochen, wenn im Zuge der Differenzierung Chromatin-Umlagerungen lebenswichtige Gene aus dem Kern des Kerns entfernen und der Tod eintritt. In malignen Zellen wird der Standard-Genschutz vor Aktivierung verletzt, die eingeschlossenen Gene erweisen sich als ständig aktiv und die Zelllinie wird in der lokalen Kultur unsterblich, dh krebsartig.